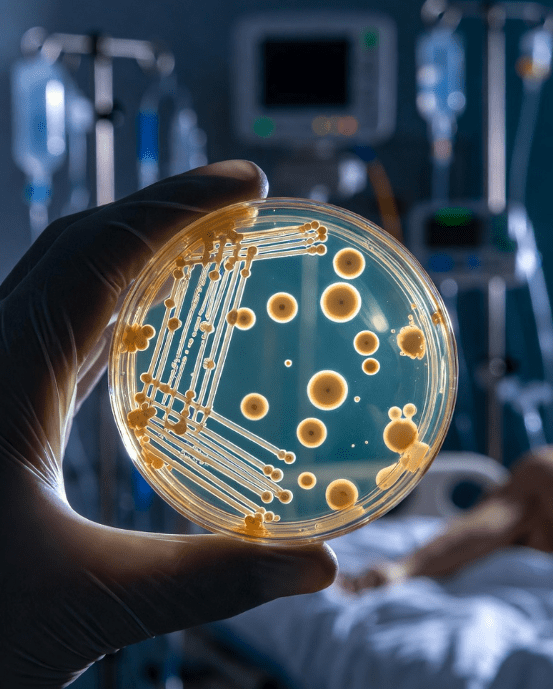

Please Support Talking-up Scotland at:
https://www.crowdfunder.co.uk/p/support-talking-up-scotland
Click on the above.
Or direct bank transfer at Sort Code 08-91-04 Account - 12266421 Name - JOHN ROBERTSON
In the Guardian today:
More than 400 lives may have been saved as a result of Martha’s rule, which lets NHS patients request a review of their care, official figures reveal. Helplines received more than 10,000 calls in the first 16 months of the scheme after its introduction in England in 2024, according to data seen by the Guardian. Thousands of patients were either moved to intensive care, received drugs they needed or benefited from other changes as a direct result of the calls. The system is named after Martha Mills, 13, who died in 2021 from sepsis after a bicycle accident. A coroner found she would probably have survived if she had been moved to the intensive care unit at King’s College hospital in London when she began deteriorating. https://www.theguardian.com/society/2026/mar/08/marthas-rule-may-have-saved-400-lives-so-far-in-england-figures-show
How under Scottish Labour, hospitals were ‘death traps’ of hospital acquired infections and how Nicola Sturgeon sorted it
The prevalence of HAI was 4.9%, 2.5%, 6.1% and 1.2% in acute, non-acute, paediatric and independent hospitals respectively [in Scotland in 2006]. https://www.journalofhospitalinfection.com/article/S0195-6701(12)00277-0/abstractThe most recent comprehensive data on hospital-acquired infections (HAIs) in Scotland comes from a 2021 study led by Glasgow Caledonian University, commissioned by the Scottish Government. This study, published in the Journal of Hospital Infection, found that approximately 1% of hospital patients in Scotland develop HAIs annually, equating to about 7,500 patients each year. This incidence rate is notably lower than previous UK estimates (7.8%) and recent European figures (3%). https://www.scotpho.org.uk/health-conditions/infections/data/healthcare-associated-infections/
So, hospital acquired infections under the SNP are between a fifth and a half of the level in 2006, under Labour, an eighth of the level in England and a third of the level in Europe.
Why, so good?
In Scotland, the decision was taken in 2008, against the background of major problems in British hospitals with infections resistant to treatment. The Scottish ministry of health [Health Secretary, Nicola Sturgeon] banned any further contracting-out of these services, so that when existing contracts expire all work returns and remains in-house. It also financed the employment of 600 extra cleaners to raise standards of cleanliness.https://www.epsu.org/article/uk-hospital-cleaning-brought-house-scotland-wales-n-ireland
New research shows that NHS hospitals that employ private cleaners are associated with a higher incidence of MRSA, a ‘superbug’ that causes life-threatening infection and has previously been linked with a lack of cleanliness…on average, the incidence of MRSA infection between 2005 and 2009 was 2.28 in every 100,000 bed days in trusts that outsourced their cleaning, compared with 1.46 bed days in trusts that used in-house cleaners –.a difference of almost 50 per cent.
The research was conducted by the University of Oxford, with the London School of Economics and Political Science, and the London School of Hygiene & Tropical Medicine.
http://www.ox.ac.uk/news/2016-12-21-nhs-hospitals-outsource-cleaning-%E2%80%98linked-higher-rates-mrsa%E2%80%99johnrobertson834health, history, news, nhs, politicsEditjohnrobertson834Edit
Please Support Talking-up Scotland at:
https://www.crowdfunder.co.uk/p/support-talking-up-scotland
Click on the above.
Or direct bank transfer at Sort Code 08-91-04 Account - 12266421 Name - JOHN ROBERTSON
Discover more from Talking-up Scotland
Subscribe to get the latest posts sent to your email.

Good decision, Minister (at the time) Nicola Sturgeon.
LikeLike
The contracting out of hospital cleaning is a major scandal. My brother died in hospital of MRSA in 2008. He had been in hospital several times and contracted it each time.
My neighbour’s brother died of MRSA around the same time. I knew many people who contracted it during a hospital visit.
Nicola Sturgeon deserves a medal for ending the death trap of dirty hospitals.
The privatisation of school cleaning was also a Thatcherite scandal. Janitors used to supervise local cleaners and arrange schedules as necessary. This was then privatised and regional supervisors would swan about in their Jaguars directing cleaners to any area on their patch. What happened if a local emergency occurred, for instance a child being sick in the classroom? A variation in schedule order would have to be submitted and a cleaner sourced from somewhere. The vomit lay on the floor until a cleaner could be found.
LikeLike